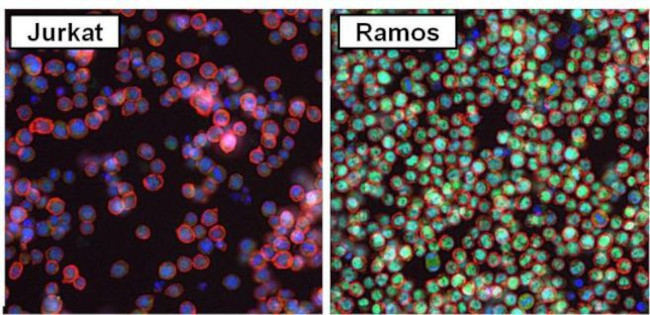
PAX5 Antibody in Immunocytochemistry (ICC/IF)

Search
Invitrogen
PAX5 Polyclonal Antibody
{{$productOrderCtrl.translations['antibody.pdp.commerceCard.promotion.promotions']}}
{{$productOrderCtrl.translations['antibody.pdp.commerceCard.promotion.viewpromo']}}
{{$productOrderCtrl.translations['antibody.pdp.commerceCard.promotion.promocode']}}: {{promo.promoCode}} {{promo.promoTitle}} {{promo.promoDescription}}. {{$productOrderCtrl.translations['antibody.pdp.commerceCard.promotion.learnmore']}}
图: 1 / 15
PAX5 Antibody (PA1-109) in ICC/IF















Please note: We are reviewing Western blot images included in the antibody testing data in our catalog, including those provided by third parties. Unless expressly labeled or annotated as “raw-unedited”, Western blot images included in the antibody testing data in our catalog may have been edited, optimized or otherwise adjusted for presentation.
产品信息
PA1-109
种属反应
已发表种属
宿主/亚型
分类
类型
抗原
偶联物
形式
浓度
规格
纯化类型
保存液
内含物
保存条件
运输条件
RRID
产品详细信息
Western blot analysis of PA1-109 detects a prominent ~45 kDa protein in PAX5 expressing human Ramos, Daudi, Gaji and mouse A20 B-cell lymphoma cells. No PAX5 was detected in negative control Jurkat cells. The 45 kDa band is enriched in immunoprecipitations from Raji lysate, however additional unknown high molecular weight bands are also enriched and detected by PA1-109. PAX5 was also specifically detected by immunofluorescence in the nuclei of Ramos cells compared to negative control Jurkat cells.
靶标信息
PAX5 is a member of the paired box (PAX) family of transcription factors. The PAX proteins are important regulators in early development and alterations in the expression of their genes are thought to contribute to neoplastic transformation. PAX5 is the B-cell lineage specific activator protein (BSAP) that is expressed at early, but not late stages, of B-cell differentiation. Its expression has also been detected in developing CNS and testis, therefore, PAX5 may not only play an important role in B-cell differentiation, but also in neural development and spermatogenesis. Mutations in the gene can result in leukemia, acute lymphoblastic 3.
仅用于科研。不用于诊断过程。未经明确授权不得转售。
生物信息学
蛋白别名: B-cell-specific transcription factor; BSAP; paired box gene 5; Paired box protein Pax-5; Pax5 variant 1; Pax5 variant 2
基因别名: BSAP; EBB-1; KLP; Pax-5; PAX5
UniProt ID: (Mouse) Q02650
Entrez Gene ID: (Mouse) 18507